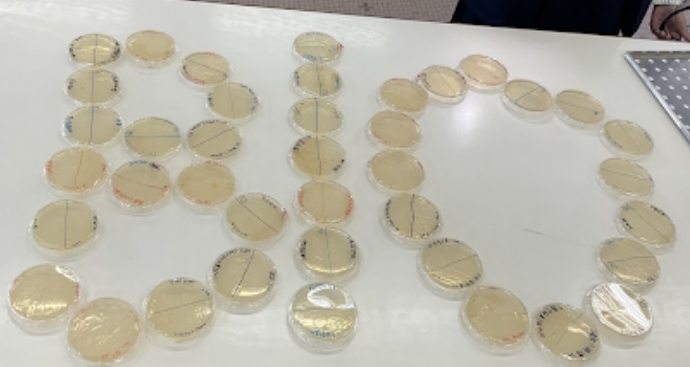
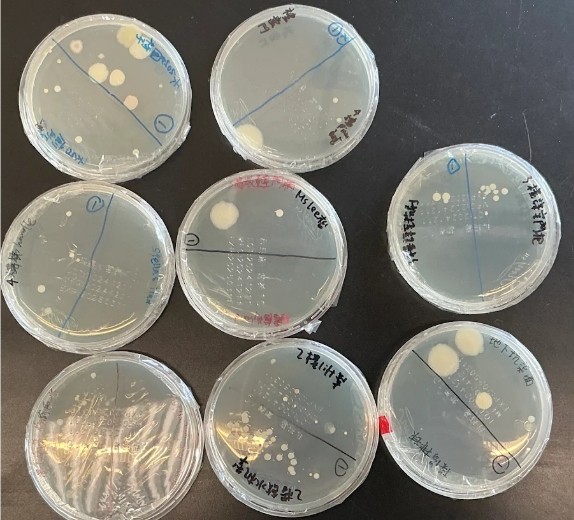

Biology Society
Objectives
-
Provide opportunities for students to engage
in a wide range of hands-on biological experiments and activities -
Broaden students’ horizons
-
Foster students’ leadership skills
Contents
Monthly meetings were held in diversified forms, mainly led by the committees
Some activities organised by the Biology Society
-
Visits to Ocean Park and dissecting lab of university
-
Talks offered by professors of universities
-
“Escape” the biology lab
-
Dissection of rat, frog and fish
-
Rainbow bouncy egg
-
Dyeing flowers
-
Laminated leaf bookmark
-
Investigation of microorganisms in BLMCSS
-
DNA extraction
-
Maker faire
Dissection of rat

Dissection of frog

Laminated leaf bookmark

Investigation of microorganisms in BLMCSS

Maker faire



